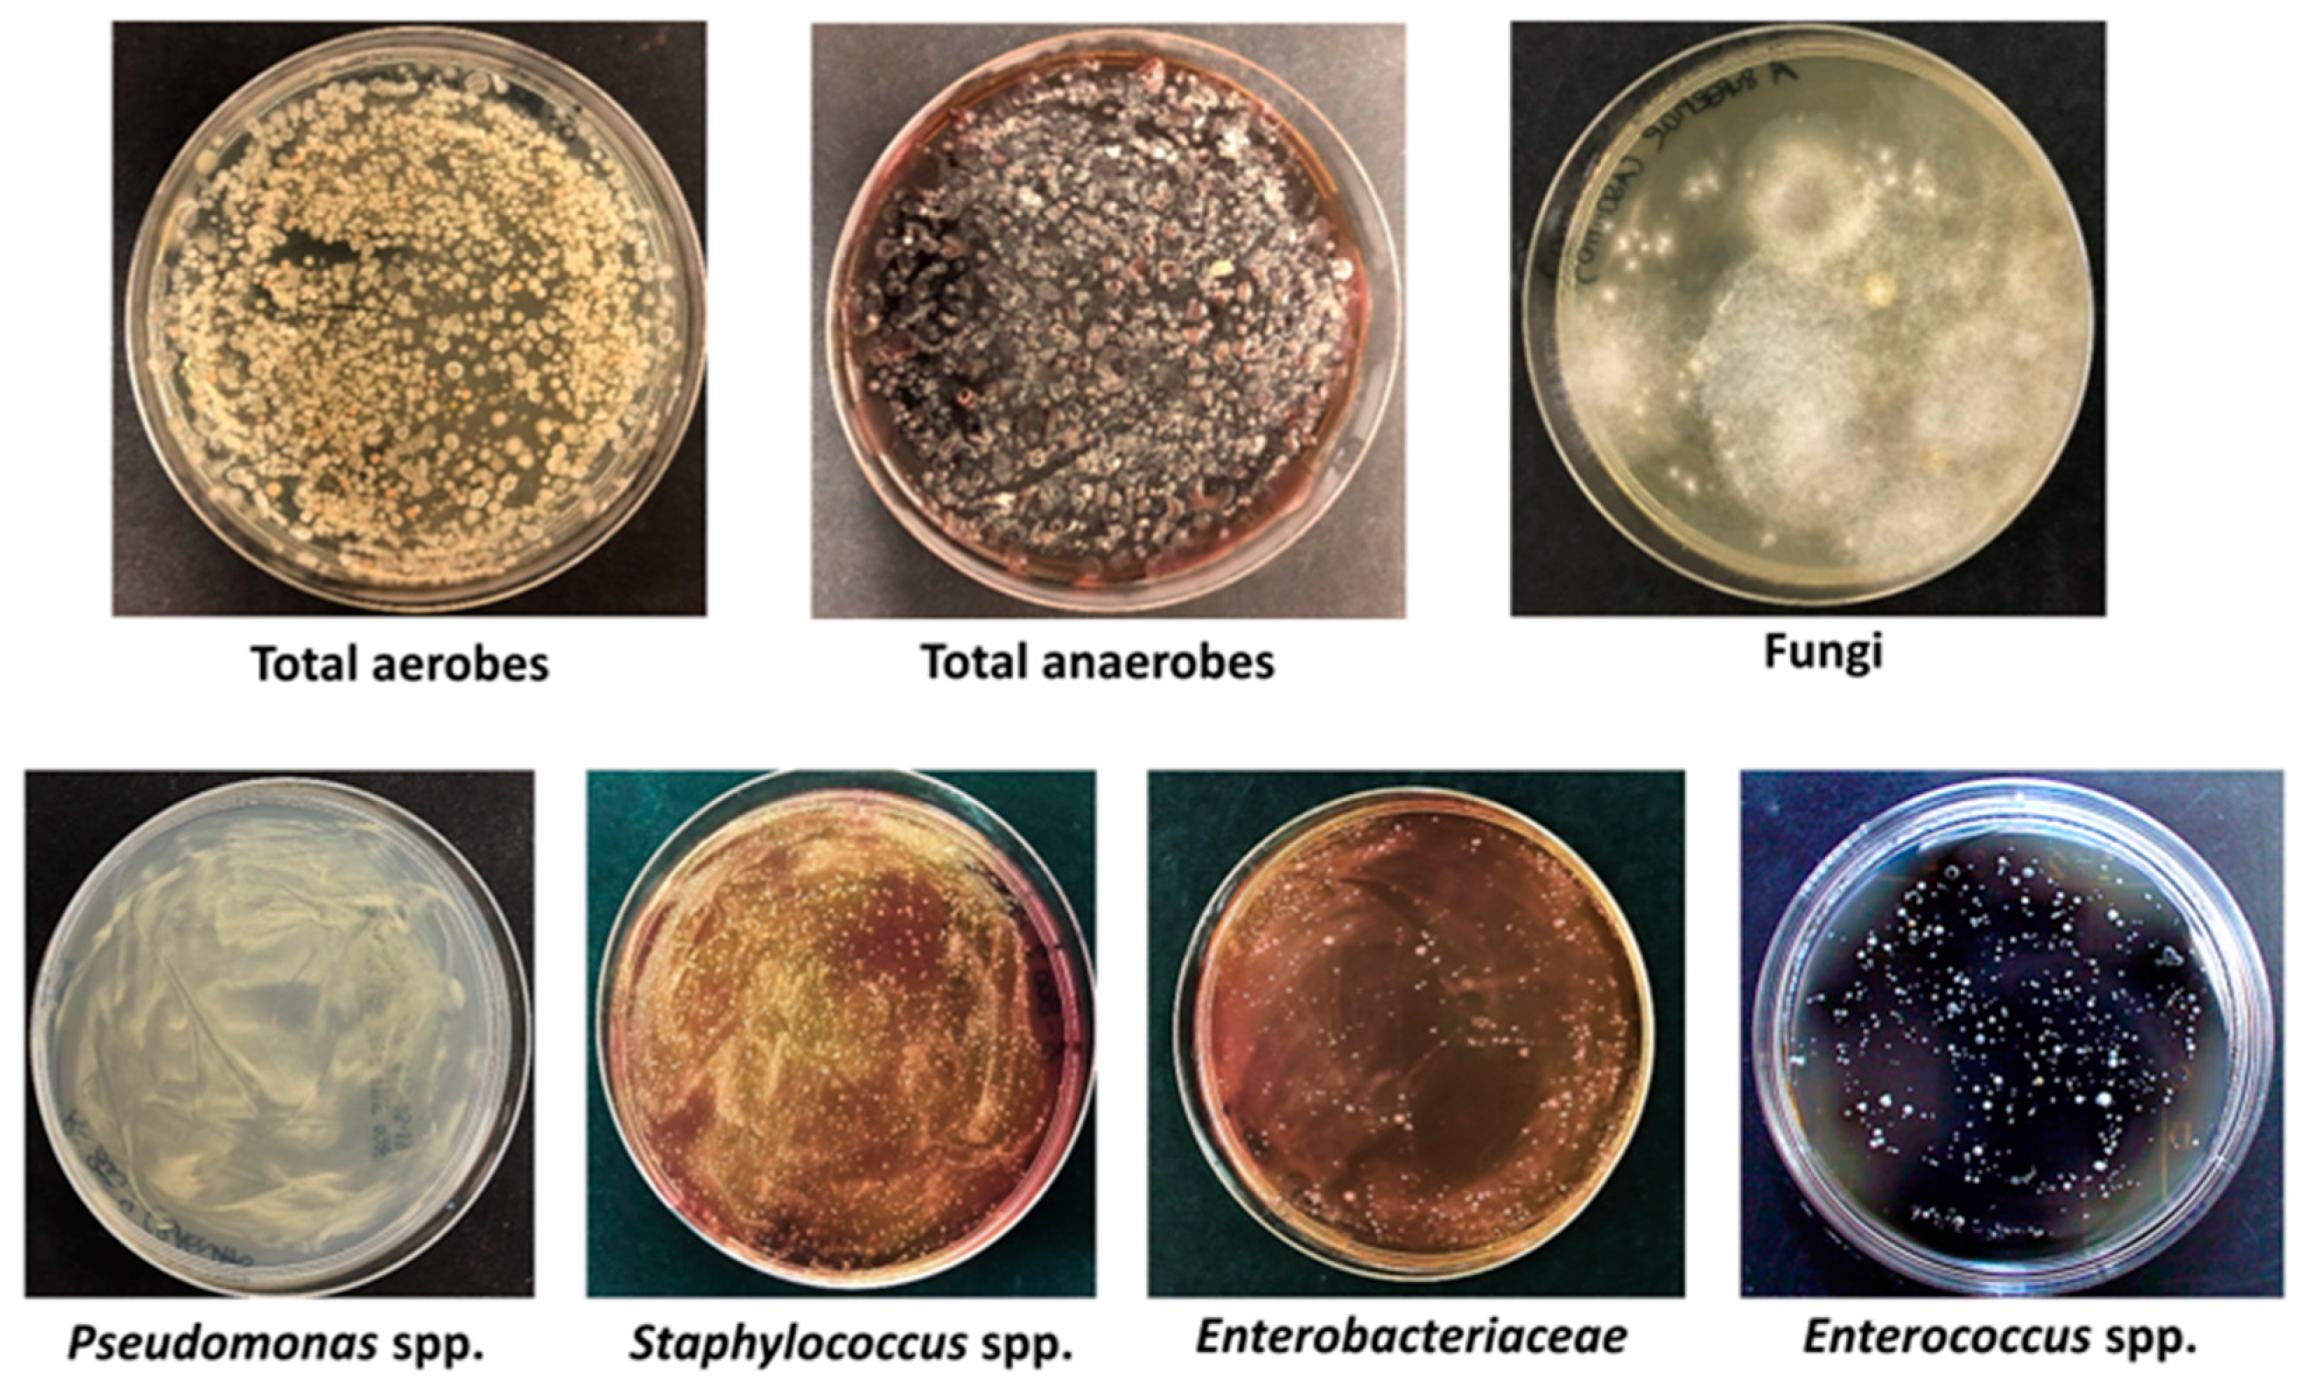
Microorganisms 11 02031 g001 Microorganisms 11 02031 g001
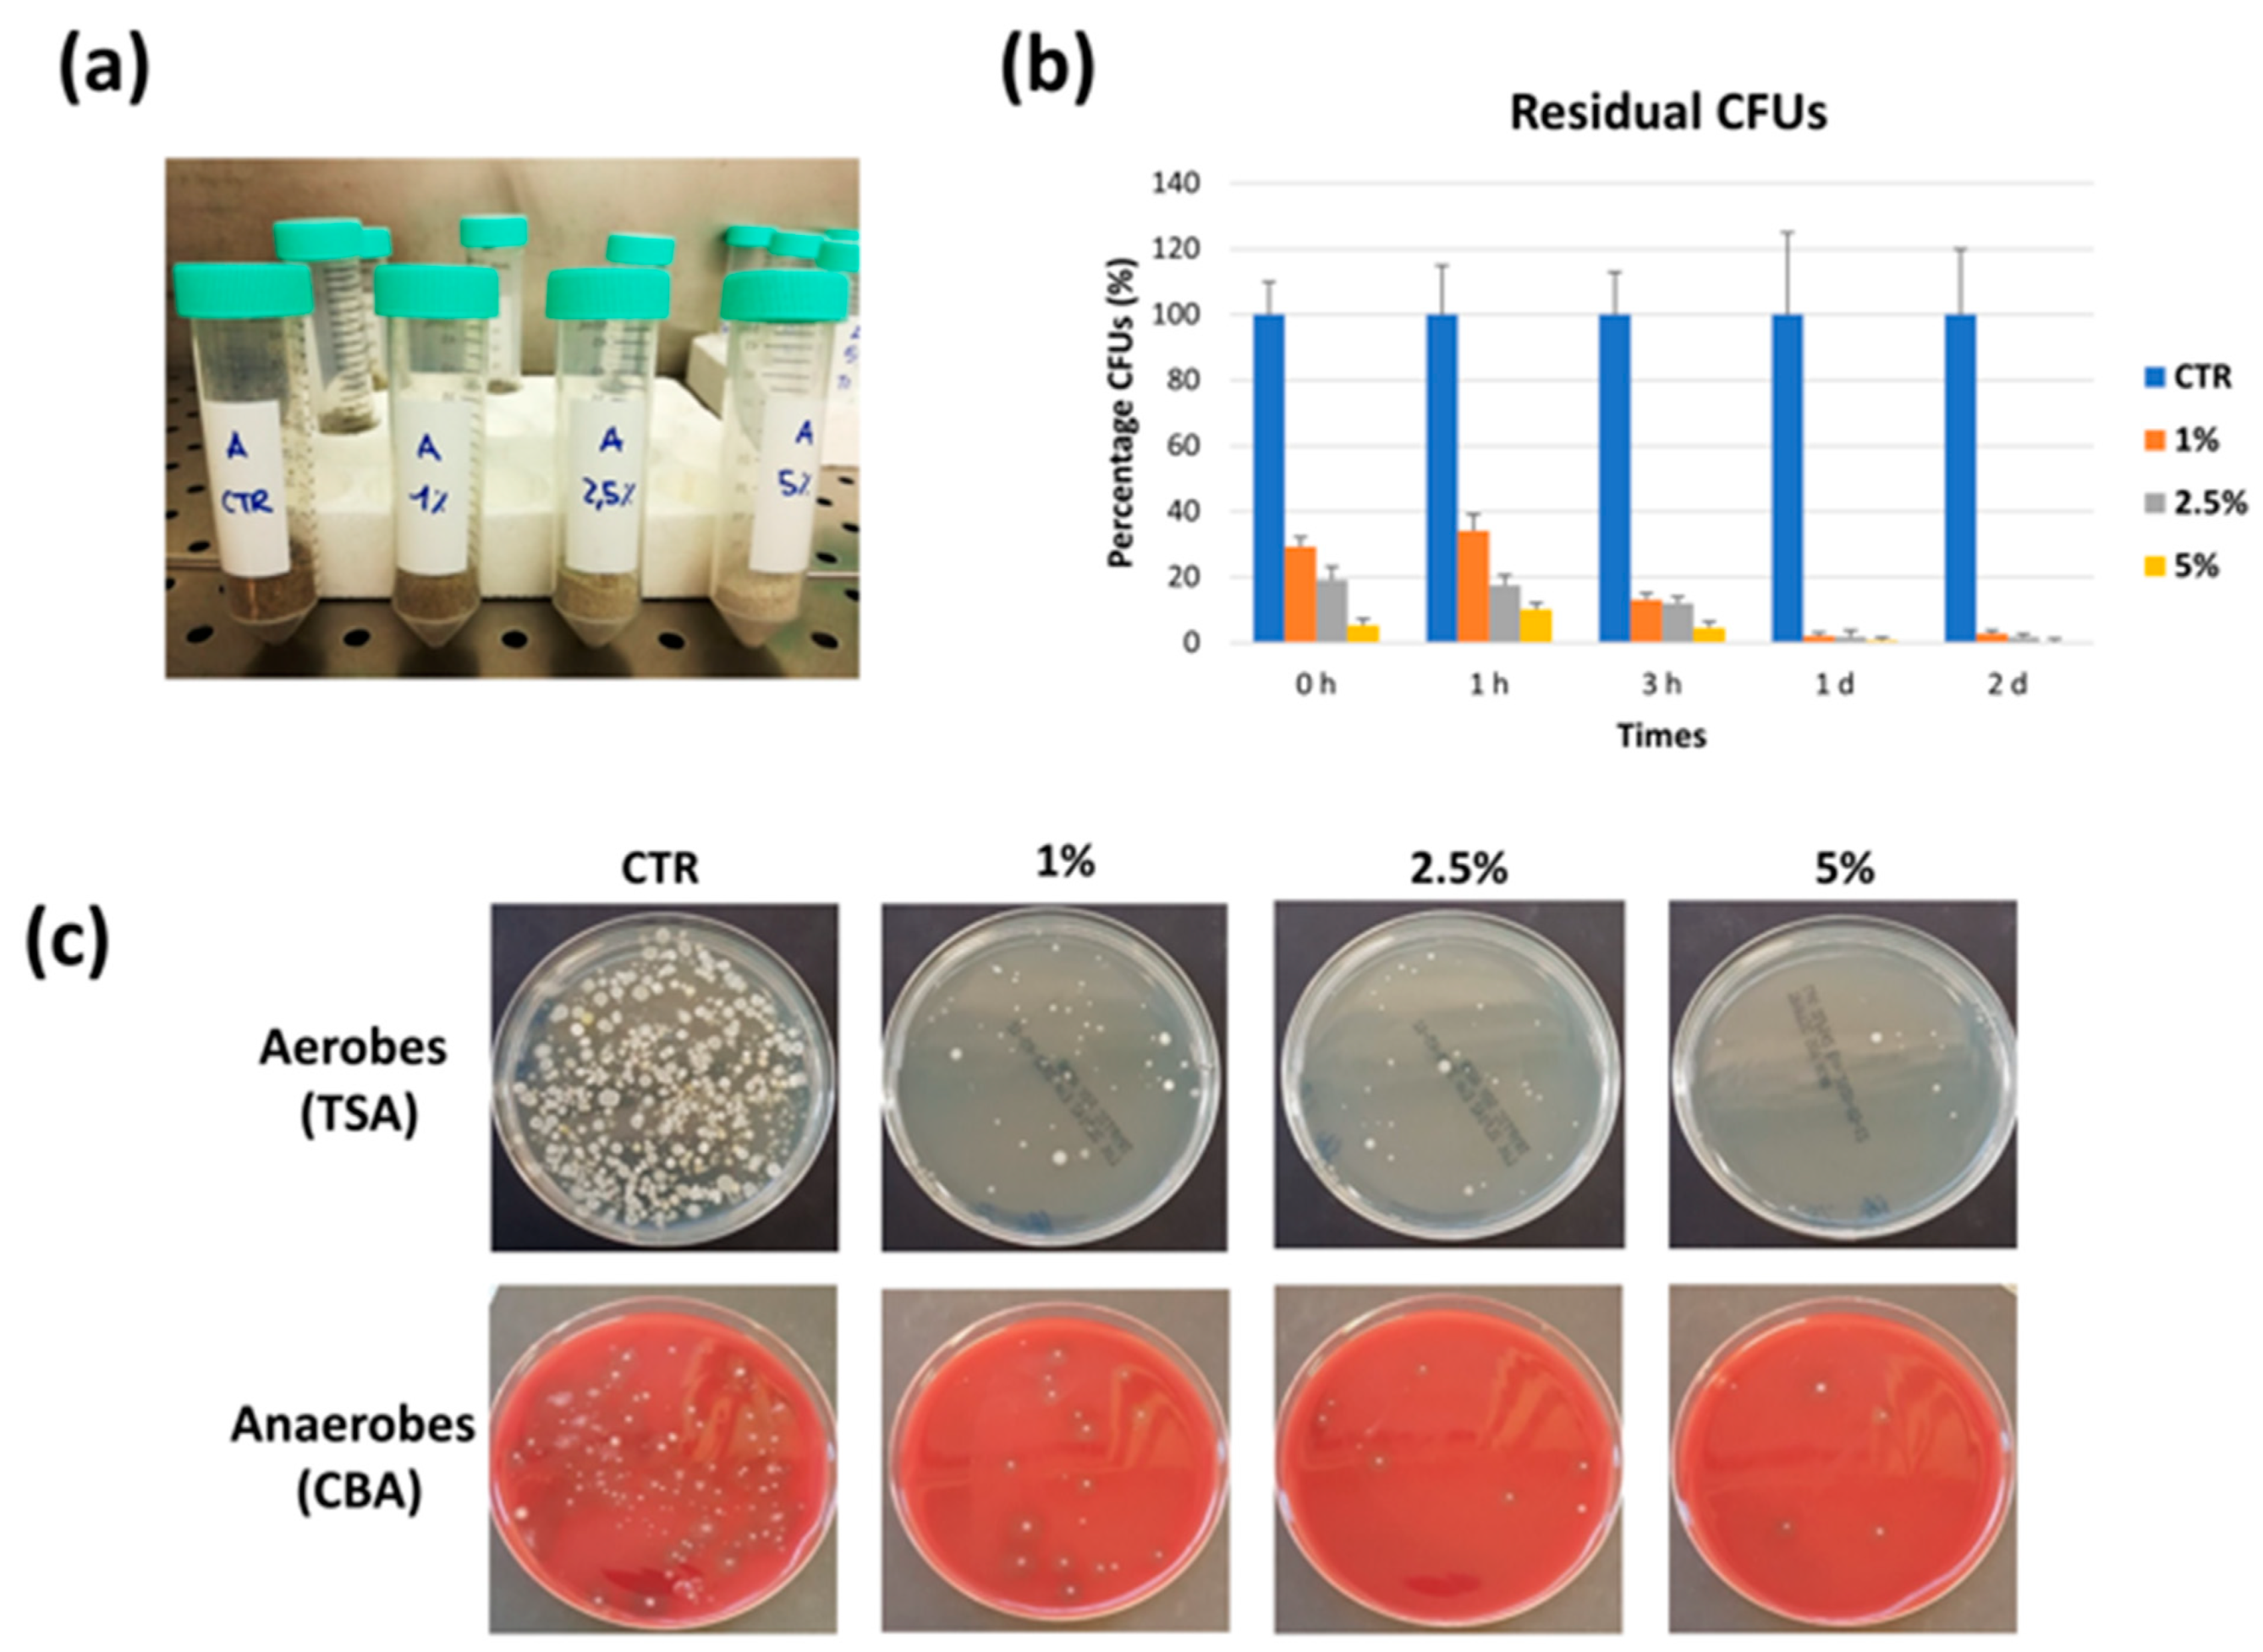
Microorganisms 11 02031 g004 Microorganisms 11 02031 g004

Characterization of the Pathogenic Potential of the Beach Sand Microbiome and Assessment of Quicklime as a Remediation Tool
Abstract
1. Introduction
2. Materials and Methods
2.1. Design of the Study
2.2. Beach Sand Sampling
2.3. Microbiological Analyses
2.4. Whole Genome Sequencing (WGS) Analyses
2.5. Microarray Analyses
2.6. In Vitro Evaluation of CaO Action
2.7. Antiviral CaO Activity Assays
2.8. Evaluation of CaO Action on Field
2.9. Statistical Analyses
3. Results
3.1. Characterization of Beach Sand Microbiame
3.2. Effect of Quicklime (CaO) on Sand Microbial Contamination
3.2.1. In Vitro Studies
3.2.2. On Field Studies
4. Discussion
5. Conclusions
Author Contributions
Funding
Data Availability Statement
Acknowledgments
Conflicts of Interest
References
- Valerio, E.; Santos, M.L.; Teixeira, P.; Matias, R.; Mendonca, J.; Ahmed, W.; Brandao, J. Microbial source tracking as a method of determination of beach sand contamination. Int. J. Environ. Res. Public Health 2022, 19, 7934. [Google Scholar] [CrossRef]
- Tamponi, C.; Knoll, S.; Tosciri, G.; Salis, F.; Dessi, G.; Cappai, M.G.; Varcasia, A.; Scala, A. Environmental contamination by dog feces in touristic areas of Italy: Parasitological aspects and zoonotic hazards. Am. J. Trop. Med. Hyg. 2020, 103, 1143–1149. [Google Scholar] [CrossRef]
- Ristic, M.; Miladinovic-Tasic, N.; Dimitrijevic, S.; Nenadovic, K.; Bogunovic, D.; Stepanovic, P.; Ilic, T. Soil and sand contamination with canine intestinal parasite eggs as a risk factor for human health in public parks in Nis (Serbia). Helminthologia 2020, 57, 109–119. [Google Scholar] [CrossRef]
- Sidhu, J.P.; Ahmed, W.; Gernjak, W.; Aryal, R.; McCarthy, D.; Palmer, A.; Kolotelo, P.; Toze, S. Sewage pollution in urban stormwater runoff as evident from the widespread presence of multiple microbial and chemical source tracking markers. Sci. Total Environ. 2013, 463–464, 488–496. [Google Scholar] [CrossRef]
- Sidhu, J.P.; Hodgers, L.; Ahmed, W.; Chong, M.N.; Toze, S. Prevalence of human pathogens and indicators in stormwater runoff in Brisbane, Australia. Water Res. 2012, 46, 6652–6660. [Google Scholar] [CrossRef] [PubMed]
- Nayak, B.; Weidhaas, J.; Harwood, V.J. La35 poultry fecal marker persistence is correlated with that of indicators and pathogens in environmental waters. Appl. Environ. Microbiol. 2015, 81, 4616–4625. [Google Scholar] [CrossRef]
- Zeki, S.; Aslan, A.; Burak, S.; Rose, J.B. Occurrence of a human-associated microbial source tracking marker and its relationship with faecal indicator bacteria in an urban estuary. Lett. Appl. Microbiol. 2021, 72, 167–177. [Google Scholar] [CrossRef]
- McQuaig, S.; Griffith, J.; Harwood, V.J. Association of fecal indicator bacteria with human viruses and microbial source tracking markers at coastal beaches impacted by nonpoint source pollution. Appl. Environ. Microbiol. 2012, 78, 6423–6432. [Google Scholar] [CrossRef] [PubMed]
- Halliday, E.; McLellan, S.L.; Amaral-Zettler, L.A.; Sogin, M.L.; Gast, R.J. Comparison of bacterial communities in sands and water at beaches with bacterial water quality violations. PLoS ONE 2014, 9, e90815. [Google Scholar] [CrossRef]
- Akanbi, O.E.; Njom, H.A.; Fri, J.; Otigbu, A.C.; Clarke, A.M. Antimicrobial susceptibility of Staphylococcus aureus isolated from recreational waters and beach sand in eastern cape province of South Africa. Int. J. Environ. Res. Public Health 2017, 14, 1001. [Google Scholar] [CrossRef] [PubMed]
- Maciel, N.O.; Johann, S.; Brandao, L.R.; Kucharikova, S.; Morais, C.G.; Oliveira, A.P.; Freitas, G.J.; Borelli, B.M.; Pellizzari, F.M.; Santos, D.A.; et al. Occurrence, antifungal susceptibility, and virulence factors of opportunistic yeasts isolated from brazilian beaches. Mem. Inst. Oswaldo. Cruz. 2019, 114, e180566. [Google Scholar] [CrossRef] [PubMed]
- Gerken, T.J.; Roberts, M.C.; Dykema, P.; Melly, G.; Lucas, D.; De Los Santos, V.; Gonzalez, J.; Butaye, P.; Wiegner, T.N. Environmental surveillance and characterization of antibiotic resistant Staphylococcus aureus at coastal beaches and rivers on the island of Hawai’i. Antibiotics 2021, 10, 980. [Google Scholar] [CrossRef] [PubMed]
- Alm, E.W.; Zimbler, D.; Callahan, E.; Plomaritis, E. Patterns and persistence of antibiotic resistance in faecal indicator bacteria from freshwater recreational beaches. J. Appl. Microbiol. 2014, 117, 273–285. [Google Scholar] [CrossRef]
- Malcheva, B.Z.; Petrov, P.G.; Stefanova, V.V. Microbiological control in decontamination of sludge from wastewater treatment plant. Processes 2022, 10, 406. [Google Scholar] [CrossRef]
- Caselli, E.; Brusaferro, S.; Coccagna, M.; Arnoldo, L.; Berloco, F.; Antonioli, P.; Tarricone, R.; Pelissero, G.; Nola, S.; La Fauci, V.; et al. Reducing healthcare-associated infections incidence by a probiotic-based sanitation system: A multicentre, prospective, intervention study. PLoS ONE 2018, 13, e0199616. [Google Scholar] [CrossRef]
- D’Accolti, M.; Soffritti, I.; Bini, F.; Mazziga, E.; Cason, C.; Comar, M.; Volta, A.; Bisi, M.; Fumagalli, D.; Mazzacane, S.; et al. Shaping the subway microbiome through probiotic-based sanitation during the COVID-19 emergency: A pre-post case-control study. Microbiome 2023, 11, 64–83. [Google Scholar] [CrossRef] [PubMed]
- Caselli, E.; Arnoldo, L.; Rognoni, C.; D’Accolti, M.; Soffritti, I.; Lanzoni, L.; Bisi, M.; Volta, A.; Tarricone, R.; Brusaferro, S.; et al. Impact of a probiotic-based hospital sanitation on antimicrobial resistance and hai-associated antimicrobial consumption and costs: A multicenter study. Infect. Drug. Resist. 2019, 12, 501–510. [Google Scholar] [CrossRef]
- Soffritti, I.; D’Accolti, M.; Fabbri, C.; Passaro, A.; Manfredini, R.; Zuliani, G.; Libanore, M.; Franchi, M.; Contini, C.; Caselli, E. Oral microbiome dysbiosis is associated with symptoms severity and local immune/inflammatory response in COVID-19 patients: A cross-sectional study. Front. Microbiol. 2021, 12, 687513–687528. [Google Scholar] [CrossRef]
- Caselli, E.; D’Accolti, M.; Vandini, A.; Lanzoni, L.; Camerada, M.T.; Coccagna, M.; Branchini, A.; Antonioli, P.; Balboni, P.G.; Di Luca, D.; et al. Impact of a probiotic-based cleaning intervention on the microbiota ecosystem of the hospital surfaces: Focus on the resistome remodulation. PLoS ONE 2016, 11, e0148857. [Google Scholar] [CrossRef]
- D’Accolti, M.; Soffritti, I.; Mazzacane, S.; Caselli, E. Fighting amr in the healthcare environment: Microbiome-based sanitation approaches and monitoring tools. Int. J. Mol. Sci. 2019, 20, 1535. [Google Scholar] [CrossRef]
- Caselli, E.; D’Accolti, M.; Soffritti, I.; Lanzoni, L.; Bisi, M.; Volta, A.; Berloco, F.; Mazzacane, S. An innovative strategy for the effective reduction of mdr pathogens from the nosocomial environment. Adv. Exp. Med. Biol. 2019, 1214, 79–91. [Google Scholar]
- Soffritti, I.; D’Accolti, M.; Cason, C.; Lanzoni, L.; Bisi, M.; Volta, A.; Campisciano, G.; Mazzacane, S.; Bini, F.; Mazziga, E.; et al. Introduction of probiotic-based sanitation in the emergency ward of a children’s hospital during the COVID-19 pandemic. Infect. Drug. Resist. 2022, 15, 1399–1410. [Google Scholar] [CrossRef]
- D’Accolti, M.; Soffritti, I.; Bonfante, F.; Ricciardi, W.; Mazzacane, S.; Caselli, E. Potential of an eco-sustainable probiotic-cleaning formulation in reducing infectivity of enveloped viruses. Viruses 2021, 13, 2227. [Google Scholar] [CrossRef] [PubMed]
- Donnenberg, M.S.; Tzipori, S.; McKee, M.L.; O’Brien, A.D.; Alroy, J.; Kaper, J.B. The role of the eae gene of enterohemorrhagic Escherichia coli in intimate attachment in vitro and in a porcine model. J. Clin. Investig. 1993, 92, 1418–1424. [Google Scholar] [CrossRef] [PubMed]
- Makino, K.; Yokoyama, K.; Kubota, Y.; Yutsudo, C.H.; Kimura, S.; Kurokawa, K.; Ishii, K.; Hattori, M.; Tatsuno, I.; Abe, H.; et al. Complete nucleotide sequence of the prophage vt2-sakai carrying the verotoxin 2 genes of the enterohemorrhagic Escherichia coli o157:H7 derived from the sakai outbreak. Genes Genet Syst. 1999, 74, 227–239. [Google Scholar] [CrossRef]
- Whitman, R.; Harwood, V.J.; Edge, T.A.; Nevers, M.; Byappanahalli, M.; Vijayavel, K.; Brandao, J.; Sadowsky, M.J.; Alm, E.W.; Crowe, A.; et al. Microbes in beach sands: Integrating environment, ecology and public health. Rev. Environ. Sci. Biotechnol. 2014, 13, 329–368. [Google Scholar] [CrossRef]
- Buczek, M. Sandy Beach Microbes: The Good, the Bad, and the Flesh-Eating; ASM, Ed.; American Society for Microbiology: Washington, DC, USA, 2017. [Google Scholar]
- Pianetti, A.; Bruscolini, F.; Sabatini, L.; Colantoni, P. Microbial characteristics of marine sediments in bathing area along Pesaro-Gabicce Coast (Italy): A preliminary study. J. Appl. Microbiol. 2004, 97, 682–689. [Google Scholar] [CrossRef] [PubMed]
- WHO. Recreational Water Quality Guidelines. 2021. Available online: https://www.who.int/news/item/13-07-2021-who-launches-guidelines-for-recreational-water-quality-as-summer-heats-up (accessed on 25 May 2023).
- Turnbull, J.D.; Russell, J.E.; Fazal, M.A.; Grayson, N.E.; Deheer-Graham, A.; Oliver, K.; Holroyd, N.; Parkhill, J.; Alexander, S. Whole-genome sequences of five strains of Kocuria rosea, nctc2676, nctc7514, nctc7512, nctc7528, and nctc7511. Microbiol. Resour. Announc. 2019, 8, e00256-19. [Google Scholar] [CrossRef] [PubMed]
- Elston, M.J.; Dupaix, J.P.; Opanova, M.I.; Atkinson, R.E. Cutibacterium acnes (formerly Proprionibacterium acnes) and shoulder surgery. Hawaii J. Health Soc. Welf. 2019, 78, 3–5. [Google Scholar]
- Zhu, M.; Zhu, Q.; Yang, Z.; Liang, Z. Clinical characteristics of patients with micrococcus luteus bloodstream infection in a chinese tertiary-care hospital. Pol. J. Microbiol. 2021, 70, 321–326. [Google Scholar] [CrossRef] [PubMed]
- Severn, M.M.; Horswill, A.R. Staphylococcus epidermidis and its dual lifestyle in skin health and infection. Nat. Rev. Microbiol. 2023, 21, 97–111. [Google Scholar] [CrossRef]
- Mueller, M.; Tainter, C.R. Escherichia coli; StatPearls: Treasure Island, FL, USA, 2023. [Google Scholar]
- Solo-Gabriele, H.; Harwood, V.; Kay, D.; Fujioka, R.; Sadowsky, M.; Whitman, R.; Brandão, J. Beach sand and the potential for infectious disease transmission: Observations and recommendations. J. Mar. Biol. Assoc. UK 2016, 96, 101–121. [Google Scholar] [CrossRef]
- Andrade Vda, C.; Zampieri Bdel, B.; Ballesteros, E.R.; Pinto, A.B.; de Oliveira, A.J. Densities and antimicrobial resistance of Escherichia coli isolated from marine waters and beach sands. Environ. Monit. Assess. 2015, 187, 342–352. [Google Scholar] [CrossRef]
- Fernandes Cardoso de Oliveira, A.J.; Ranzani de Franca, P.T.; Pinto, A.B. Antimicrobial resistance of heterotrophic marine bacteria isolated from seawater and sands of recreational beaches with different organic pollution levels in southeastern Brazil: Evidences of resistance dissemination. Environ. Monit. Assess. 2010, 169, 375–384. [Google Scholar] [CrossRef] [PubMed]
- de Oliveira, A.J.; Pinhata, J.M. Antimicrobial resistance and species composition of Enterococcus spp. Isolated from waters and sands of marine recreational beaches in southeastern Brazil. Water Res. 2008, 42, 2242–2250. [Google Scholar] [CrossRef] [PubMed]
- Carducci, A.; Federigi, I.; Balestri, E.; Lardicci, C.; Castelli, A.; Maltagliati, F.; Zhao, H.; Menicagli, V.; Valente, R.; De Battisti, D.; et al. Virus contamination and infectivity in beach environment: Focus on sand and stranded material. Mar. Pollut Bull. 2022, 185, 114342–114353. [Google Scholar] [CrossRef]
- Choi, H.Y.; Bang, I.H.; Kang, J.H.; Min, S.C. Development of a microbial decontamination system combining washing with highly activated calcium oxide solution and antimicrobial coating for improvement of mandarin storability. J. Food Sci. 2019, 84, 2190–2198. [Google Scholar] [CrossRef] [PubMed]
- Chen, J.; Hu, L.; Chen, N.; Jia, R.; Ma, Q.; Wang, Y. The biocontrol and plant growth-promoting properties of streptomyces alfalfae xn-04 revealed by functional and genomic analysis. Front. Microbiol. 2021, 12, 745766–745782. [Google Scholar] [CrossRef]
- CDC. Nocardiosis. 2016. Available online: https://www.cdc.gov/nocardiosis/index.html (accessed on 25 May 2023).
- Toubiana, M.; Salles, C.; Tournoud, M.G.; Licznar-Fajardo, P.; Zorgniotti, I.; Tremelo, M.L.; Jumas-Bilak, E.; Robert, S.; Monfort, P. Monitoring urban beach quality on a summer day: Determination of the origin of fecal indicator bacteria and antimicrobial resistance at Prophete Beach, Marseille (France). Front. Microbiol. 2021, 12, 710346. [Google Scholar] [CrossRef]
- El-Mansy, A. Evaluation of the effect of quicklime on some organisms from different ecosystems in Egypt: Morphological perspective. World Environ. 2020, 10, 10–16. [Google Scholar]
- De Giglio, O.; Narracci, M.; Apollonio, F.; Triggiano, F.; Acquaviva, M.I.; Caroppo, C.; Diella, G.; Di Leo, A.; Fasano, F.; Giandomenico, S.; et al. Microbiological and chemical characteristics of beaches along the Taranto Gulf (Ionian Sea, southern Italy). Environ. Monit. Assess. 2022, 194, 448. [Google Scholar] [CrossRef] [PubMed]
- Bonanno Ferraro, G.; Suffredini, E.; Mancini, P.; Veneri, C.; Iaconelli, M.; Bonadonna, L.; Montagna, M.T.; De Giglio, O.; La Rosa, G. Pepper mild mottle virus as indicator of pollution: Assessment of prevalence and concentration in different water environments in Italy. Food Environ. Virol. 2021, 13, 117–125. [Google Scholar] [CrossRef] [PubMed]
- Brandao, J.; Valerio, E.; Weiskerger, C.; Verissimo, C.; Sarioglou, K.; Novak Babic, M.; Solo-Gabriele, H.M.; Sabino, R.; Rebelo, M.T. Strategies for monitoring microbial life in beach sand for protection of public health. Int. J. Environ. Res. Public Health 2023, 20, 5710. [Google Scholar] [CrossRef] [PubMed]

| Genus/Species | CFU/g 1 |
|---|---|
| Pseudomonas spp. | 1.6 × 105 ± 1.1 × 103 |
| Staphylococcus spp. | 1.9 × 104 ± 6.7 × 102 |
| Enterococcus spp. | 1.1 × 103 ± 1.9 × 102 |
| Enterobacteriaceae spp. | 4.4 × 103 ± 2.2 × 102 |
| Clostridium spp. | 1.5 × 104 ± 1.3 × 102 |
| Fungi | 4.8 × 102 ± 5.4 × 10 |
| Species | Positivitity | Ct 1 |
|---|---|---|
| Arcobacter butzleri | ++ | 28.94 |
| Arcobacter skirrowii | + | 31.00 |
| Bifidobacterium adolescentis | + | 30.04 |
| Campylobacter upsaliensis | + | 30.97 |
| Clostridium perfringens | +/− | 36.82 |
| Desulfovibrio desulfuricans | ++ | 29.42 |
| Enterococcus gallinarum, Enterococcus casseliflavus | ++ | 26.91 |
| Enterococcus faecalis | +/− | 37.50 |
| Enterococcus faecium | +/− | 37.16 |
| Morganella morganii | ++ | 29.87 |
| Ruminococcus bromii | + | 33.27 |
| Shigella dysenteriae (Salmonella bongori) | ++ | 27.83 |
| Streptococcus suis | +/− | 36.98 |
| Vibrio choleare | ++ | 22.74 |
| Vibrio vulnificus | + | 34.07 |
| Yersinia enterocolitica | + | 31.41 |
| eae (intimin adherence protein) | ++ | 29.09 |
| stx2A (Shiga-like toxin II) | +/− | 37.99 |
| Condition | 1 h | 2 h | 1 d | 2 d |
|---|---|---|---|---|
| CTR (untreated) | 9.38 | 9.01 | 8.84 | 9.28 |
| CaO 1% | 12.40 | 12.31 | 11.38 | 9.57 |
| CaO 2.5% | 12.23 | 12.80 | 11.97 | 10.85 |
| CaO 5% | 12.68 | 12.72 | 12.07 | 12.02 |
| Condition | 1 h | 2 h | 1 d | 2 d | 7 d | 14 d | 26 d | 47 d | 63 d | 100 d |
|---|---|---|---|---|---|---|---|---|---|---|
| CTR | 9.04 | 8.98 | 9.01 | 9.08 | 9.73 | 8.99 | 9.01 | 8.96 | 9.05 | 9.07 |
| CaO 1% | 11.34 | 11.45 | 11.98 | 12.01 | 12.22 | 11.01 | 8.89 | 8.85 | 9.05 | 8.89 |
| CaO 2% | 12.04 | 12.21 | 12.30 | 12.38 | 12.36 | 11.54 | 8.87 | 8.95 | 9.03 | 8.99 |
| CaO 2% (n.a.w.) | 12.26 | 12.31 | 12.32 | 12.25 | 12.36 | 11.31 | 9.05 | 8.86 | 8.99 | 9.02 |
| CaO 3% | 12.09 | 12.42 | 12.45 | 12.40 | 12.43 | 11.67 | 11.21 | 9.67 | 9.06 | 9.01 |
| CaCO3 3% | 8.99 | 9.01 | 9.10 | 8.98 | 8.96 | 8.96 | 8.95 | 8.74 | 8.95 | 8.92 |
| Core Species | Mean RA (%) 1 | |
|---|---|---|
| CTR | CaO 2 | |
| Priesta megaterium | 11.53 | 13.97 |
| Streptomyces alfalfae | 6.36 | 8.01 |
| Pseudomonas putida | 3.57 | 3.25 |
| Cutibacterium acnes | 3.06 | 0.44 |
| Nocardioides sp. CF8 | 4.31 | 0.76 |
| Priestia flexa | 3.46 | 0.94 |
| Fusarium oxysporum | 0.32 | 0.35 |
| Nocardioides dokdonensis | 3.80 | 0.46 |
| Sphingomonas koreensis | 3.13 | 0.36 |
| Pseudarthrobacter phenanthrenivorans | 2.07 | 0.24 |
| Bacillus halotolerans | 1.33 | 0.51 |
| Pseudomonas aeruginosa | 0.34 | - |
| Sinorhizobium meliloti | 0.79 | 0.94 |
| Pseudomonas stutzeri | 1.26 | 0.24 |
| Bacillus circulans | 0.90 | 0.09 |
| Bordetella petrii | 1.20 | - |
| Ensifer adhaerens | 0.17 | - |
| Achromobacter spanius | 0.65 | - |
| Rhodococcus hoagii | 0.59 | 0.55 |
| Sphingopyxis macrogoltabida | 0.51 | 0.71 |
| Arthrobacter sp. ZXY-2 | 0.65 | - |
| Microbacterium sp. Y-01 | 1.95 | - |
| Nocardioides euryhalodurans | 0.19 | - |
| Cellulosimicrobium sp. TH-20 | 1.06 | - |
| Tardibacter chloracetimidivorans | 1.11 | - |
| Nocardioides seonyuensis | 0.11 | - |
| Chroococcidiopsis thermalis | 0.008 | - |
| Pseudorhizobium banfieldiae | 0.60 | 0.37 |
| Nocardioides sp. JS614 | 0.84 | - |
| Priestia filamentosa | 0.23 | 0.15 |
| Achromobacter sp. MFA1 R4 | 0.47 | 0.50 |
| Streptomyces rubrolavendulae | 0.62 | - |
| Metabacillus litoralis | 0.30 | - |
| Ralstonia pickettii | 0.37 | - |
| Arthrobacter sp. YN | 0.21 | - |
| Tsuneonella amylolytica | 0.05 | 0.11 |
| Paenibacillus mucilaginosus | 0.15 | 0.03 |
| Time | Sample | Alpha-Index 1 | CaO/CTR Alpha-Index 2 | p |
|---|---|---|---|---|
| 1 h | CTR | 8.86 | 1.00 | n.s. |
| CaO 1% | 7.89 | 0.89 | n.s. | |
| CaO 2% | 8.41 | 0.95 | n.s. | |
| CaO 3% | 8.90 | 1.00 | n.s. | |
| 1 d | CTR | 10.52 | 1.00 | n.s. |
| CaO 1% | 9.96 | 0.94 | n.s. | |
| CaO 2% | 8.56 | 0.81 | n.s. | |
| CaO 3% | 8.01 | 0.76 | 0.05 | |
| 2 d | CTR | 13.61 | 1.00 | n.s. |
| CaO 1% | 12.59 | 0.92 | n.s. | |
| CaO 2% | 11.33 | 0.83 | n.s. | |
| CaO 3% | 10.69 | 0.78 | 0.05 | |
| 7 d | CTR | 10.09 | 1.00 | n.s. |
| CaO 1% | 8.62 | 0.85 | n.s. | |
| CaO 2% | 7.79 | 0.77 | 0.05 | |
| CaO 3% | 5.57 | 0.55 | 0.01 | |
| 14 d | CTR | 13.72 | 1.00 | n.s. |
| CaO 1% | 12.75 | 0.92 | n.s. | |
| CaO 2% | 10.01 | 0.72 | 0.05 | |
| CaO 3% | 6.01 | 0.44 | 0.01 | |
| 35 d | CTR | 11.49 | 1.00 | n.s. |
| CaO 1% | 11.14 | 0.96 | n.s. | |
| CaO 2% | 10.92 | 0.95 | n.s. | |
| CaO 3% | 9.67 | 0.84 | n.s. | |
| 63 d | CTR | 12.24 | 1.00 | n.s. |
| CaO 1% | 11.91 | 0.97 | n.s. | |
| CaO 2% | 12.24 | 1.00 | n.s. | |
| CaO 3% | 12.82 | 1.04 | n.s. |
Disclaimer/Publisher’s Note: The statements, opinions and data contained in all publications are solely those of the individual author(s) and contributor(s) and not of MDPI and/or the editor(s). MDPI and/or the editor(s) disclaim responsibility for any injury to people or property resulting from any ideas, methods, instructions or products referred to in the content. |
© 2023 by the authors. Licensee MDPI, Basel, Switzerland. This article is an open access article distributed under the terms and conditions of the Creative Commons Attribution (CC BY) license (https://creativecommons.org/licenses/by/4.0/).
Share and Cite
Soffritti, I.; D’Accolti, M.; Bini, F.; Mazziga, E.; Volta, A.; Bisi, M.; Rossi, S.; Viroli, F.; Balzani, M.; Petitta, M.; et al. Characterization of the Pathogenic Potential of the Beach Sand Microbiome and Assessment of Quicklime as a Remediation Tool. Microorganisms 2023, 11, 2031. https://doi.org/10.3390/microorganisms11082031
Soffritti I, D’Accolti M, Bini F, Mazziga E, Volta A, Bisi M, Rossi S, Viroli F, Balzani M, Petitta M, et al. Characterization of the Pathogenic Potential of the Beach Sand Microbiome and Assessment of Quicklime as a Remediation Tool. Microorganisms. 2023; 11(8):2031. https://doi.org/10.3390/microorganisms11082031
Chicago/Turabian StyleSoffritti, Irene, Maria D’Accolti, Francesca Bini, Eleonora Mazziga, Antonella Volta, Matteo Bisi, Silvia Rossi, Francesco Viroli, Marcello Balzani, Marco Petitta, and et al. 2023. "Characterization of the Pathogenic Potential of the Beach Sand Microbiome and Assessment of Quicklime as a Remediation Tool" Microorganisms 11, no. 8: 2031. https://doi.org/10.3390/microorganisms11082031
APA StyleSoffritti, I., D’Accolti, M., Bini, F., Mazziga, E., Volta, A., Bisi, M., Rossi, S., Viroli, F., Balzani, M., Petitta, M., Mazzacane, S., & Caselli, E. (2023). Characterization of the Pathogenic Potential of the Beach Sand Microbiome and Assessment of Quicklime as a Remediation Tool. Microorganisms, 11(8), 2031. https://doi.org/10.3390/microorganisms11082031

